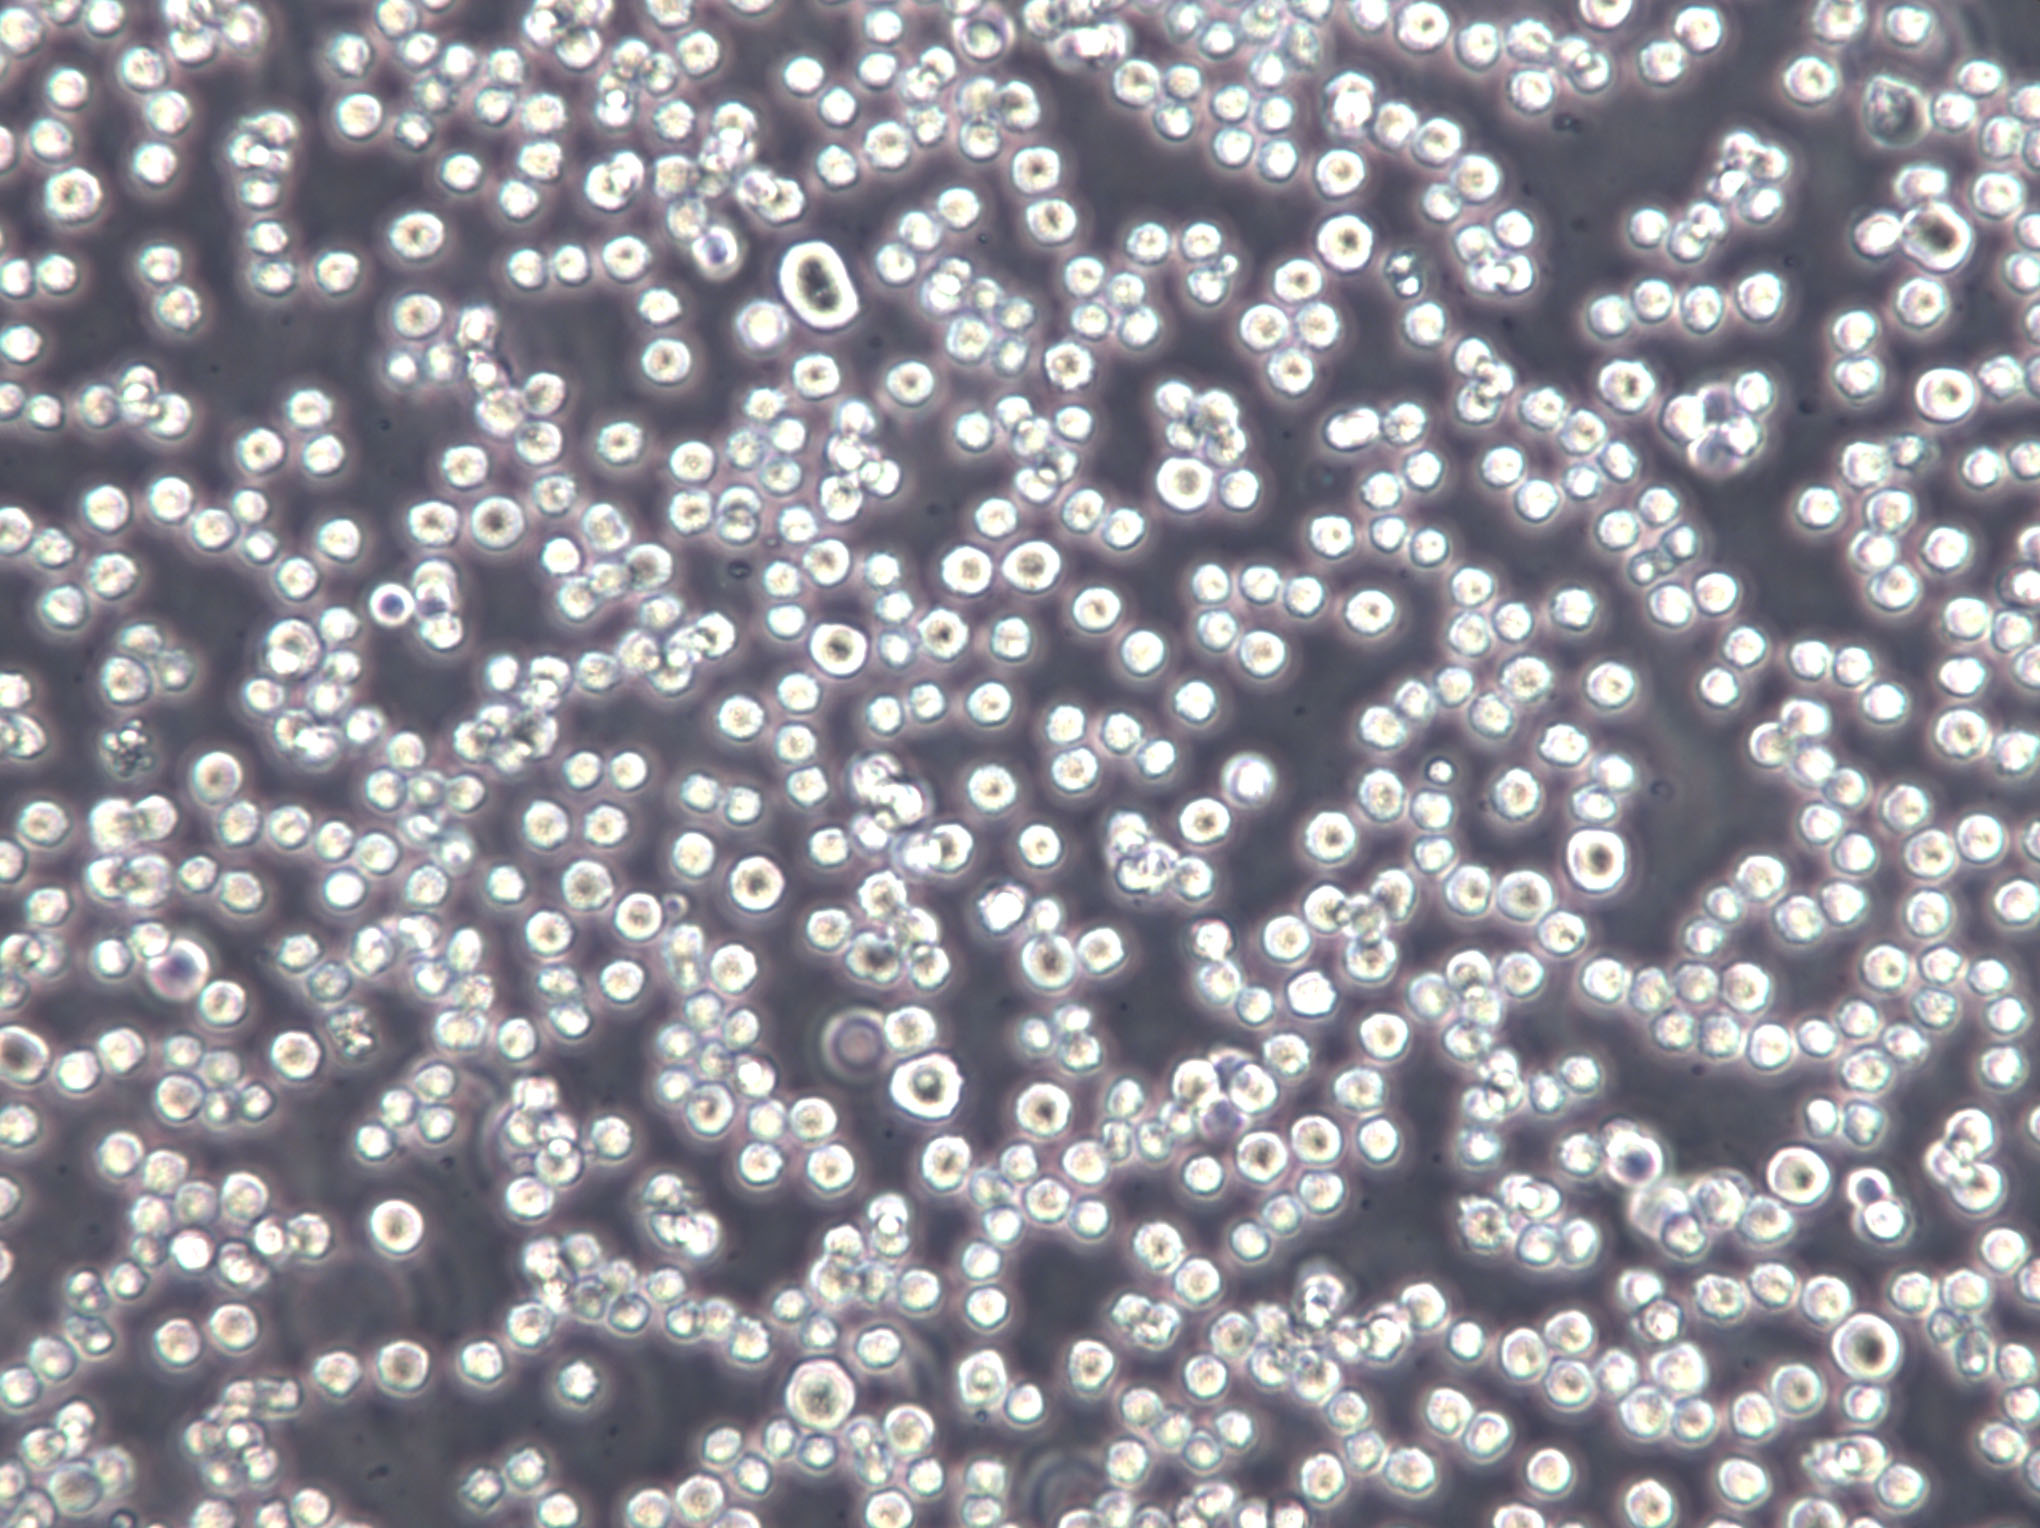
胰蛋白胨葡萄糖酵母浸膏肉汤培养基基础

"胰蛋白胨葡萄糖酵母浸膏肉汤培养基基础
产品规格:250g/瓶
英文名称:TPGY Broth(TPGYT Base)
微生物培养基结块原因:1、实验室的相对湿度很高2、药品瓶盖好像开封之后没有密封好;建议放点硅胶在附近除湿,开封后的干粉培养基都是放在干燥器中,防止湿度太大结块。因为湿度太大等客观因素造成的,培养基还是可以使用的。像 MC、MRS 带有吐温、卵磷脂、半胱安酸等成分的培养基是开封后,放冰箱,我们实验室都是放冰箱的,效果不错的。还有开过封的在开封日起一个月内用完。当然培养基结块严重了,就不能再使用了,这样会对计数产生影响的。结块不利细菌培养,结果观察容易造成不准确,所以不能用。有些人会说溶解,再利用,个人也不建议。
马铃薯浸出液琼脂培养基;英文名称:Potato Infusion Agar;产品别名:马铃薯浸出液琼脂培养基基础;马铃薯浸出液琼脂培养基;使用说明:NULL;产品规格:250g/瓶;产品用途:用于布鲁氏菌的培养
3%NaCl鸟安酸脱羧酶试验培养基;英文名称:Ornithine Decarboxylase Test Mediu with 3%NaCl;产品别名:3%NaCl鸟安酸脱羧酶试验培养基基础;3%NaCl鸟安酸脱羧酶试验培养基;使用说明:NULL;产品规格:250g/瓶;产品用途:用于弧菌的鸟安酸脱羧酶试验
三糖铁琼脂培养基[TSI];英文名称:Triple Sugar Iron Agar Medium;产品别名:三糖铁琼脂培养基基础[TSI];三糖铁琼脂培养基[TSI];使用说明:称取本品63.4g于1L蒸馏水或去离子水中,加热煮沸至完全溶解,分装试管,121℃高压灭菌15分钟或115℃灭菌30分钟,灭菌结束后请摇匀,制成高层斜面,备用;产品规格:250g/瓶;产品用途:用于细菌生化试验
胰酪胨大豆琼脂培养基;英文名称:Soybean-Casein Digest Agar;产品别名:胰酪胨大豆琼脂培养基基础;TSA培养基;胰酪胨大豆琼脂培养基(TSA);使用说明:称取本品40.0g,加热搅拌溶解于1000ml纯化水中,分装三角瓶,121℃高压灭菌15分钟,备用;产品规格:250g/瓶;产品用途:用于抑菌剂效力(中国药典2010)
产品用途:用于肉毒梭菌增菌培养,添加1:250胰蛋白酶配制成TPGYT
胰蛋白胨葡萄糖酵母浸膏肉汤培养基基础
使用说明:称取本品80.0g于1L蒸馏水或去离子水中,煮沸溶解,分装试管15ml/支,上面覆盖一层0.3-0.4cm厚的液体石蜡,121 ℃高压灭菌10分钟。临用前使用蒸汽或煮沸10-15分钟以排除游离氧。如需制备TYGPT培养基,需在排除游离氧后,无菌操作每15ml基础液加入1ml1.5%胰酶溶液(1:250)。
公司集产品研发、生产、质控、仓储、物流、办公为一体。产品通过了ISO17025认可实验室质控把关,生产车间达到了GMP生产要求,拥有近两千平米的万级洁净生产车间,掌握并运用先进生产工艺建立了全自动液体培养基灌装线、全自动产品包装流水线、全自动平板培养基生产线等多条国内领先的现代化生产线。公司不断积极拓展市场、扩充产品应用领域、广泛吸纳高素质人才、引进国际领先技术、树立了极具强大竞争力的自主品牌影响力。
乙基紫叠氮钠肉汤培养基;英文名称:Ethyl Violet Azide Broth;产品别名:乙基紫叠氮钠肉汤培养基基础;乙基紫叠氮钠肉汤培养基;使用说明:称取本品35.8g于1L蒸馏水或去离子水中,加热煮沸至完全溶解,分装,121℃高压灭菌15分钟,冷却,备用;产品规格:250g/瓶;产品用途:用于链球菌的增菌培养
胰蛋白胨琼脂培养基;英文名称:Tryptone Agar Medium;产品别名:胰蛋白胨琼脂培养基基础;胰蛋白胨琼脂培养基;使用说明:NULL;产品规格:250g/瓶;产品用途:用于布鲁氏菌属检验
牛津琼脂培养基;英文名称:Oxford Agar Base;产品别名:牛津琼脂培养基基础;OXA培养基;牛津琼脂培养基(OXA);使用说明:称取本品5.85g于100ml蒸馏水或去离子水中,加热煮沸1分钟以上至完全溶解,121℃高压灭菌15分钟,灭菌结束后请迅速摇匀,以防琼脂沉积于器皿底部而凝固,冷至50-55℃,加入多粘菌素E、溶液、黄溶液各1支,摇匀,倾注平板,备用;产品规格:250g/瓶;产品用途:用于李氏菌分离,每100ml添加多粘菌素E、溶液、黄溶液各1支
EG琼脂培养基;英文名称:EG Agar Medium;产品别名:EG琼脂培养基基础;EG琼脂培养基;使用说明:称取本品39.1g于950ml蒸馏水或去离子水中,加热煮沸至完全溶解,分装,121℃高压灭菌15分钟或115℃灭菌30分钟,灭菌结束后请摇匀,以防琼脂沉积于器皿底部而凝固,冷至50℃,无菌操作加入50ml无菌马血,摇匀,倾注平皿,备用;产品规格:250g/瓶;产品用途:用于厌氧菌计数,每95ml培养基需添加5ml无菌马血
CH培养基[含抗生素];英文名称:Cysteine Heart Blood Agar with antibiotics;产品别名:CH培养基基础[含抗生素];CH培养基[含抗生素];使用说明:NULL;产品规格:250g/瓶;产品用途:用于弯曲菌培养,每100ml添加2支溶液、2支硫酸多粘菌素B溶液、1支新生霉素储备液和10ml无菌脱纤维绵羊全血
Dey/Engley中和琼脂培养基;英文名称:Dey/Engley Neutralizing Agar Base;产品别名:Dey/Engley中和琼脂培养基基础;Dey/Engley中和琼脂培养基;使用说明:称取本品49.0g于1L蒸馏水或去离子水中(可按比例增加或减少配制量),每升培养基添加一支吐温80,加热煮沸溶解,分装,121℃高压灭菌15分钟,灭菌后请摇匀,以防琼脂沉积于器皿底部,备用;产品规格:250g/瓶;产品用途:用于化妆品样品的制备和细菌培养,每200ml添加1支吐温80
培养基灭菌注意事项:加水:打开灭菌锅盖,向锅内加水到水位线。立式消毒锅用已煮开过的水,以便减少水垢在锅内的积存。注意水要加够,防止灭菌过程中干锅。装料、加盖:灭菌材料放好后,关闭灭菌器盖,采用对角式均匀拧紧锅盖上的螺旋,使蒸汽锅密闭,勿使漏气。 排气:打开排气口,用电炉加热,待水煮沸后,水蒸气和空气一起从排气孔排出,当有大量蒸汽排出时,维持5分钟,使锅内冷空气完全排净。升压、保压和降压:当锅内冷空气排净时,即可关闭排气阀,压力开始上升。当压力上升至所需压力时,控制电压以维持恒温,并开始计算灭菌时间,待时间达到要求(一般培养基和器皿灭菌控制在121摄氏度,20分钟)后,停止加热,待压力降至接近“0”时,打开放气阀。注意不能过早过急地排气,否则会由于瓶内压力下降的速度比锅内慢而造成瓶内液体冲出容器之外。
Cary-Blair氏运送培养基英文名称:Cary-Blair Transport Medium
改良NBB琼脂培养基英文名称:NBB Agar Base,Modified
芽孢杆菌培养基英文名称:Bacillus Medium Base
B12琼脂培养基英文名称:B12 Assay Medium
肉肝琼脂培养基英文名称:Meat Liver Agar
淀粉水解培养基英文名称:Starch Hydrolysis Medium
m-HPC琼脂培养基英文名称:Heterotrophic Plate Count Agar
豆芽汁蔗糖培养基英文名称:Soybean sprout Extract Sucrose Medium
联合固氮菌培养基英文名称:Endophytic Diazotrophs Medium
葡萄糖蛋白胨培养基英文名称:Glucose Peptone Medium
BL琼脂培养基;英文名称:BL Agar Base;产品别名:BL琼脂培养基基础;BL琼脂培养基;使用说明:称取本品58.0g于1L蒸馏水或去离子水中,加热煮沸至完全溶解,分装,115℃高压灭菌20分钟,灭菌结束后请摇匀,以防琼脂沉积于器皿底部而凝固,冷至50℃,缓缓加入5%脱纤维马血(建议提前在35℃左右保温),轻轻混匀,倾注平板。本品因含吐温-80,故易结团,但不影响产品质量;产品规格:250g/瓶;产品用途:用于双歧杆菌的分离和培养,需添加5%脱纤维马血
盐肉汤培养基;英文名称:Selenite-F Broth(Selenite Broth, Selenite Enrichme;产品别名:盐肉汤培养基基础;SF培养基;盐肉汤培养基(SF);使用说明:称取本品23.0g于1L蒸馏水或去离子水中,加热溶解(避免过分加热),分装,备用。本品禁止高压灭菌。本品宜当天配制当天使用;产品规格:250g/瓶;产品用途:用于粪便样品、水、食品中沙门氏菌的选择性增菌
甘露醇盐琼脂培养基 ;英文名称:Mannitol Salt Agar;产品别名:甘露醇盐琼脂培养基基础 ;甘露醇盐琼脂培养基 ;使用说明:称取本品110.0g于1L蒸馏水或去离子水中,煮沸溶解1分钟,补水至1000ml,分装,121℃灭菌15分钟或116℃30分钟,灭菌结束后请摇匀以防琼脂沉底于底部而凝固,冷至55℃左右,备用;产品规格:250g/瓶;产品用途:用于金黄色葡萄球菌选择性分离(日本标准)
AA液体培养基;英文名称:AA Fluid Medium;产品别名:AA液体培养基基础;AA液体培养基;使用说明:称取本品22.7g于1L蒸馏水或去离子水中,使用NaOH或HCl调节pH使灭菌后pH5.7-5.9(25℃),煮沸溶解,分装,115℃高压灭菌30分钟,备用。本品为可能有少量不溶物;产品规格:500g/瓶;产品用途:用于愈伤组织悬浮培养
马铃薯葡萄糖琼脂培养基[日本标准用];英文名称:Potato dextrose agar;产品别名:马铃薯葡萄糖琼脂培养基基础[日本标准用];PDA培养基;马铃薯葡萄糖琼脂培养基[日本标准用](PDA);使用说明:称取本品39.0g于1L蒸馏水或去离子水中,加热煮沸持续1分钟以上使溶解,分装,121℃灭菌15分钟,灭菌结束后请摇匀,以防琼脂沉积于器皿底部而凝固,冷至50℃左右,倾注平皿,备用;产品规格:250g/瓶;产品用途:用于霉菌和酵母菌计数
模拟葡萄汁培养基;英文名称:MSM medium Base;产品别名:模拟葡萄汁培养基基础;MSM培养基;模拟葡萄汁培养基(MSM);使用说明:称取本品207g于1L蒸馏水或去离子水中,微温溶解,调节pH至5.8,过滤除菌,每1升培养基添加1支脂肪酸溶液,混匀,备用;产品规格:1KG/瓶;产品用途:用于摸拟葡萄汁对真菌的培养,每升培养基添加1支脂肪酸溶液
Amies运送培养基;英文名称:Amies Transport Medium;产品别名:Amies运送培养基基础;Amies运送培养基;使用说明:称取本品13.25克,溶于1000ml蒸馏水,分装于试管中。121℃高压灭菌15分钟,备用;产品规格:250g/瓶;产品用途:用于致病菌标本的采集、运输和保存
四号琼脂培养基;英文名称:No.4 Agar Base;产品别名:四号琼脂培养基基础;四号琼脂培养基;使用说明:称取本品60.0g,加热溶解于1000ml蒸馏水中,冷至50-55℃时,每1000ml培养基中加入无菌1%亚碲酸钾溶液1ml,混匀,倾入无菌平皿,备用;产品规格:250g/瓶;产品用途:用于霍乱弧菌选择性分离,每200ml添加1支亚碲酸钾溶液
品红钠琼脂培养基;英文名称:Fuchsin Basic Sodium Sulfite Agar;产品别名:品红钠琼脂培养基基础;品红钠琼脂培养基;使用说明:称取本品5.45g于100ml蒸馏水或去离子水中(可按比例增加或减少配制量),添加无水乙醇2ml,115℃高压灭菌20分钟,灭菌结束后请摇匀,以防琼脂沉积于器皿底部而凝固,备用;产品规格:250g/瓶;产品用途:用于总大肠菌群滤膜法计
胰蛋白胨葡萄糖酵母浸膏肉汤培养基基础
缓冲MUG琼脂培养基;英文名称:Buffered MUG Agar;产品别名:缓冲MUG琼脂培养基基础;BMA培养基;缓冲MUG琼脂培养基(BMA);使用说明:称取本品24.53g于1L蒸馏水或去离子水中,加热煮沸至完全溶解,分装,121℃高压灭菌15分钟,灭菌结束后请摇匀,倾注平板,凝固,备用;产品规格:100g/瓶;产品用途:用于滤膜法测定大肠杆菌
假单胞菌琼脂培养基;英文名称:CN Agar Base;产品别名:假单胞菌琼脂培养基基础;CN琼脂基础;假单胞菌琼脂培养基(CN);使用说明:称取本品5.26g于100ml蒸馏水或去离子水中,加入1ml,121℃高压灭菌15分钟或115℃灭菌30分钟,灭菌结束后请摇匀,以防琼脂沉积于器皿底部而凝固,冷至50℃,无菌操作加入1支萘啶酮酸1.5mg,混匀,倾注平板,凝固,备用。本品因含十六烷基三甲基Br化铵可能稍显浑浊;产品规格:250g/瓶;产品用途:用于绿脓杆菌滤膜法测定,每100ml添加、萘啶酮酸溶液各1支
改良CCD琼脂培养基;英文名称:Modified CCD Agar Base;产品别名:改良CCD琼脂培养基基础;改良CCD琼脂培养基;使用说明:称取本品51.5g于1L蒸馏水或去离子水,加热煮沸1分钟以上使彻底溶解,分装试管,121℃高压灭菌15分钟,冷至45-50℃,每100ml培养基添加1支弯曲菌分离琼脂添加剂(头孢哌酮、两性霉素B、利福平),混匀,倾注平皿,凝固,备用;产品规格:250g/瓶;产品用途:用于弯曲菌选择性分离,每100ml添加1支 弯曲菌分离琼脂添加剂(头孢哌酮、两性霉素B、利福平)
Trans-Vag肉汤培养基;英文名称:Trans-Vag Broth Base;产品别名:Trans-Vag肉汤培养基基础;Trans-Vag肉汤培养基;使用说明:称取本品30.0g于1L蒸馏水或去离子水中,加热煮沸至完全溶解,分装,121℃高压灭菌15分钟,冷至55℃以下,无菌操作,每100ml培养基添加1支0.8mg无菌庆大霉素和1支1.5mg无菌萘啶酮酸,混匀,备用;产品规格:250g/瓶;产品用途:用于链球菌的选择性分离,每100ml添加庆大霉素溶液、萘啶酮酸溶液各1支
葡萄糖蛋白胨琼脂培养基;英文名称:Dextrose Peptone Agar;产品别名:葡萄糖蛋白胨琼脂培养基基础;葡萄糖蛋白胨琼脂培养基;使用说明:称取本品43.5g于1L蒸馏水或去离子水中,加热至完全溶解,分装,121℃高压灭菌15分钟,冷至50~55℃,每200ml培养基中添加1支Cl霉素溶液,制成含抗生素的葡萄糖蛋白胨琼脂,混匀,备用;产品规格:250g/瓶;产品用途:用于真菌的检测,选择性添加Cl霉素溶液
EB肉汤增菌液培养基;英文名称:EB Enrichment Broth;产品别名:EB肉汤增菌液培养基基础;EB肉汤增菌液培养基;使用说明:NULL;产品规格:250g/瓶;产品用途:用于李斯特氏菌的选择性增菌,每225ml添加1支黄溶液、2支萘啶酮酸溶液、1支溶液
肉肝琼脂培养基;英文名称:Meat Liver Agar;产品别名:肉肝琼脂培养基基础;肉肝琼脂培养基;使用说明:称取本品34.2g于1L蒸馏水或去离子水中,加热煮沸至完全溶解,分装,121℃高压灭菌15分钟,灭菌结束后请摇匀,以防琼脂沉积于器皿底部而凝固,备用;产品规格:250g/瓶;产品用途:用于厌氧菌的培养
硫酸盐还原菌培养基D;英文名称:Postgate’s Medium D for Sulfate Reducers;产品别名:硫酸盐还原菌培养基基础D;硫酸盐还原菌培养基D;使用说明:NULL;产品规格:250g/瓶;产品用途:无硫酸盐,用于脱硫微生物的培养
TYCSB培养基;英文名称:Tryptone Yeast Cystine Sucrose Bacitracin Medium;产品别名:TYCSB培养基基础;TYCSB培养基;使用说明:称取本品25.0g于100ml蒸馏水或去离子水中(可按比例增加或减少配制量),加热煮沸至完全溶解,分装,121℃高压灭菌15分钟,冷至55℃,每100ml添加1支杆菌肽(20U杆菌肽),混匀,倾注平板,备用;产品规格:500g/瓶;产品用途:用于变异链球菌的分离, 每100ml添加1支杆菌肽
碎肉肉汤培养基;英文名称:Chopped Meat Broths(CM);产品别名:碎肉肉汤培养基基础;碎肉肉汤培养基;使用说明:称取本品50.0g于1L蒸馏水或去离子水中,微温溶解,分装试管,向试管中添加适量庖肉牛肉粒(占液体1/3高度),121℃高压灭菌15分钟,冷却至50℃以下,无菌操作每100ml添加0.5mg(Cl化血红素)、0.1mg(维生素K1)各1支,备用;产品规格:250g/瓶;产品用途:用于厌氧菌特别是专性厌氧菌的培养,含VK ,需添加庖肉牛肉粒
植物胨酵母琼脂培养基;英文名称:Phytone Yeast Extract Agar;产品别名:植物胨酵母琼脂培养基基础;植物胨酵母琼脂培养基;使用说明:NULL;产品规格:250g/瓶;产品用途:用于皮肤真菌尤其是癣状毛癣菌等致病性真菌的选择性分离
DYS耶尔森菌琼脂培养基;英文名称:DYS Yersinaia Agar;产品别名:DYS耶尔森菌琼脂培养基基础;DYS耶尔森菌琼脂培养基;使用说明:NULL;产品规格:250g/瓶;产品用途:用于小肠结肠炎耶尔森氏菌的分离培养
安苄青霉素麦康凯琼脂培养基;英文名称:Ampicillin MacConey Agar Base;产品别名:安苄青霉素麦康凯琼脂培养基基础;安苄青霉素麦康凯琼脂培养基;使用说明:称取本品52.0g,加热溶解于1000ml蒸馏水中,121℃高压灭菌15分钟,冷却至50℃时,每200ml加入一支安苄青霉素溶液(1mg),混匀,倾入无菌平皿,备用;产品规格:250g/瓶;产品用途:用于嗜水气单胞菌的分离培养,每100ml添加1支安苄青霉素溶液
阿须贝氏无氮培养基;英文名称:Ashby’s Nitrogen-Free Agar;产品别名:阿须贝氏无氮培养基基础;阿须贝氏无氮培养基;使用说明:称取本品30.6g于1L蒸馏水或去离子水中,加热煮沸至完全溶解,分装,121℃高压灭菌15分钟,灭菌结束后请摇匀,备用;产品规格:250g/瓶;产品用途:用于固氮菌的培养
改良TGC流体培养基[无指示剂];英文名称:TGC Medium without Indicator ,Fluid;产品别名:改良TGC流体培养基基础[无指示剂];改良TGC流体培养基[无指示剂];使用说明:称取本品30.0g于1L蒸馏水或去离子水中,煮沸溶解,分装,121℃高压灭菌15分钟,迅速冷却,备用;产品规格:250g/瓶;产品用途:用于无菌检验
改良NBB肉汤培养基;英文名称:NBB Broth Base,Modified;产品别名:改良NBB肉汤培养基基础;改良NBB肉汤培养基;使用说明:称取本品66.3g,加入500ml蒸馏水和500ml脱气啤酒中,加热搅拌溶解,煮沸1分钟,使其彻底溶解,121℃高压灭菌15分钟,备用;产品规格:250g/瓶;产品用途:用于啤酒中微生物的检测
Aliz-gal琼脂培养基;英文名称:Aliz-gal Agar;产品别名:Aliz-gal琼脂培养基基础;Aliz-gal琼脂培养基;使用说明:称取本品46.7g于1L蒸馏水或去离子水中,加热煮沸至完全溶解,分装,116℃高压灭菌10分钟,灭菌结束后请摇匀,以防琼脂沉积于器皿底部而凝固,备用;产品规格:100g/瓶;产品用途:用于大肠菌群快速检测
三糖铁琼脂培养基[TSI];英文名称:Triple Sugar Iron Agar Medium;产品别名:三糖铁琼脂培养基基础[TSI];三糖铁琼脂培养基[TSI];使用说明:称取本品63.4g于1L蒸馏水或去离子水中,加热煮沸至完全溶解,分装试管,121℃高压灭菌15分钟或115℃灭菌30分钟,灭菌结束后请摇匀,制成高层斜面,备用;产品规格:250g/瓶;产品用途:用于细菌生化试验
赖安酸铁琼脂培养基;英文名称:Lysine Iron Agar;产品别名:赖安酸铁琼脂培养基基础;LIA培养基;赖安酸铁琼脂培养基(LIA);使用说明:称取本品32.0g,加热溶解于1000ml蒸馏水中,分装于13x100mm试管中,每管4ml。121℃高压灭菌15分钟,冷至60℃时,制成斜面,斜面长2.5cm,底部长4cm;产品规格:250g/瓶;产品用途:用于赖安酸脱梭、脱安及复合生化试验(FDA)
BG 11琼脂培养基;英文名称:Medium BG 11 for Cyanobacteria;产品别名:BG 11琼脂培养基基础;BG 11琼脂培养基;使用说明:称取本品11.69g于1L蒸馏水或去离子水中,加热煮沸1分钟使彻底溶解,分装,121℃高压灭菌15分钟,冷却,备用;产品规格:500g/瓶;产品用途:用于蓝细菌的培养
BPL琼脂培养基;英文名称:BPL Agar;产品别名:BPL琼脂培养基基础;BPL琼脂培养基;使用说明:称取本品42.0g于1L蒸馏水或去离子水中(可按比例增加或减少配制量),加热煮沸至完全溶解,分装,121℃高压灭菌15分钟,灭菌结束后请摇匀,以防琼脂沉积于器皿底部而凝固,备用;产品规格:250g/瓶;产品用途:用于沙门氏菌的选择性分离与鉴别
抗生素培养基2号;英文名称:Medium 2(Penassay Base Agar);产品别名:抗生素培养基基础2号;抗生素培养基2号;使用说明:称取本品25.5g,加热溶解于1000ml纯化水中,分装,121℃高压灭菌15分钟,备用;产品规格:250g/瓶;产品用途:用于微生物方法测定抗生素效
安苄青霉素麦康凯琼脂培养基;英文名称:Ampicillin MacConey Agar Base;产品别名:安苄青霉素麦康凯琼脂培养基基础;安苄青霉素麦康凯琼脂培养基;使用说明:称取本品52.0g,加热溶解于1000ml蒸馏水中,121℃高压灭菌15分钟,冷却至50℃时,每200ml加入一支安苄青霉素溶液(1mg),混匀,倾入无菌平皿,备用;产品规格:250g/瓶;产品用途:用于嗜水气单胞菌的分离培养,每100ml添加1支安苄青霉素溶液
SBG磺胺增菌液培养基;英文名称:SBG Sulfa Enrichment;产品别名:SBG磺胺增菌液培养基基础;SBG磺胺增菌液培养基;使用说明:称取本品24.2g于1L蒸馏水或去离子水中,微温溶解,加热煮沸5-10分钟,避免过分加热,不可高压灭菌,分装;产品规格:250g/瓶;产品用途:含磺胺嘧啶,用于沙门氏菌选择性增菌
艰难梭菌选择性琼脂培养基;英文名称:Clostridium difficile Selective Agar;产品别名:艰难梭菌选择性琼脂培养基基础;CDA培养基;艰难梭菌选择性琼脂培养基(CDA);使用说明:NULL;产品规格:250g/瓶;产品用途:用于艰难梭菌的选择性分离.每400ml添加1支D-环丝安酸溶液、1支头孢西丁溶液、3支50%卵黄盐水悬液、4ml马血
根瘤菌培养基[YM];英文名称:Nodule Bacteria Medium YM;产品别名:根瘤菌培养基基础[YM];根瘤菌培养基[YM];使用说明:称取本品30.0g于1L蒸馏水或去离子水中,加热煮沸至完全溶解,分装,121℃高压灭菌15分钟或115℃灭菌30分钟,灭菌结束后请摇匀,以防琼脂沉积于器皿底部而凝固,备用;产品规格:250g/瓶;产品用途:用于根瘤菌的培养
RVS肉汤培养基;英文名称:Rappaport Vassiliadis Salmonella Enrichment Broth;产品别名:RVS肉汤培养基基础;RVS肉汤培养基;使用说明:称取本品27.1g,加热搅拌溶解于1000ml蒸馏水中,充分混匀,分装,121℃高压灭菌15分钟,保存于4 -10℃冰箱,备用。注:放置于42℃水浴培养;产品规格:250g/瓶;产品用途:用于沙门氏菌选择性增菌
3%NaCl鸟安酸脱羧酶试验培养基;英文名称:Ornithine Decarboxylase Test Mediu with 3%NaCl;产品别名:3%NaCl鸟安酸脱羧酶试验培养基基础;3%NaCl鸟安酸脱羧酶试验培养基;使用说明:NULL;产品规格:250g/瓶;产品用途:用于弧菌的鸟安酸脱羧酶试验
改良爱德华培养基;英文名称:Edwards Medium Base,Modified;产品别名:改良爱德华培养基基础;改良爱德华培养基;使用说明:称取本品41.0g于1L蒸馏水或去离子水中,另加入0.33g,加热煮沸至完全溶解,分装,115℃灭菌20分钟,灭菌结束后请摇匀,冷至50℃,添加5-7%牛血或羊血,混匀,倾注平板;产品规格:250g/瓶;产品用途:用于无乳链球菌的选择性分离,每升添加0.33g和5~7%无菌脱纤维绵羊全血
7.5%Cl化钠肉汤培养基;英文名称:7.5%Sodium Chloride Broth;产品别名:7.5%Cl化钠肉汤培养基基础;7.5%Cl化钠肉汤培养基;使用说明:称取本品88.0g于1L蒸馏水或纯化水中,微温溶解,分装,121℃高压灭菌15分钟或115℃灭菌30分钟,备用;产品规格:250g/瓶;产品用途:用于微生态活菌制品中金黄色葡萄球菌的检测
GC琼脂培养基;英文名称:GC Agar Base;产品别名:GC琼脂培养基基础;GC琼脂培养基;使用说明:称取本品36.0g于1L蒸馏水或去离子水中,加热煮沸至完全溶解,分装,121℃高压灭菌15分钟或115℃灭菌30分钟,冷却至55℃左右,无菌操作,每100ml培养基中添加IsoVitaleX添加剂、VCN抑菌剂、无菌血红蛋1g各1支,混匀,倾注平板,备用;产品规格:250g/瓶;产品用途:用于致病性奈瑟氏菌的分离
抗生素培养基32号;英文名称:Medium 32;产品别名:抗生素培养基基础32号;抗生素培养基32号;使用说明:称取本品31.0g于1L蒸馏水或去离子水中(可按比例增加或减少配制量),加热煮沸至完全溶解,分装,121℃高压灭菌15分钟,冷却,备用;产品规格:250g/瓶;产品用途:用于微生物方法测定抗生素效价
硅酸盐细菌液体培养基;英文名称:Silicate Bacteria Fluid Medium;产品别名:硅酸盐细菌液体培养基基础;硅酸盐细菌液体培养基;使用说明:称取本品23.6克,加热溶解于1000ml蒸馏水中,分装,116℃高压灭菌30分钟,备用;产品规格:250g/瓶;产品用途:用于硅酸盐细菌的培养
Cl化镁孔雀绿增菌液培养基;英文名称:Rappaport-Vassiliadis Medium;产品别名:Cl化镁孔雀绿增菌液培养基基础;RV/MM培养基;Cl化镁孔雀绿增菌液培养基(RV/MM);使用说明:称取本品31.5g于1L蒸馏水或去离子水中,加热至完全溶解,分装试管,115℃高压灭菌15分钟,冷却,备用;产品规格:250g/瓶;产品用途:用于沙门氏菌选择性增菌
SB肉汤培养基;英文名称:Super Broth;产品别名:SB肉汤培养基基础;SB肉汤培养基;使用说明:NULL;产品规格:250g/瓶;产品用途:用于基因工程大肠杆菌的高密度发酵
BPL琼脂培养基;英文名称:BPL Agar;产品别名:BPL琼脂培养基基础;BPL琼脂培养基;使用说明:称取本品42.0g于1L蒸馏水或去离子水中(可按比例增加或减少配制量),加热煮沸至完全溶解,分装,121℃高压灭菌15分钟,灭菌结束后请摇匀,以防琼脂沉积于器皿底部而凝固,备用;产品规格:250g/瓶;产品用途:用于沙门氏菌的选择性分离与鉴别
豆芽汁葡萄糖培养基;英文名称:Soybean sprout Extract Glucose Medium;产品别名:豆芽汁葡萄糖培养基基础;豆芽汁葡萄糖培养基;使用说明:称取本品60.0g于1L蒸馏水或去离子水中,加热至完全溶解,分装,116℃高压灭菌30分钟,冷却,备用;产品规格:250g/瓶;产品用途:用于真菌尤其是霉菌的培养
酵母安基酸缺陷型合成液体培养基[组安酸缺陷/SC-His];英文名称:Yeast Synthetic Drop-out Fluid Medium without Hist;产品别名:酵母安基酸缺陷型合成液体培养基基础[组安酸缺陷/SC-His];酵母安基酸缺陷型合成液体培养基[组安酸缺陷/SC-His];使用说明:NULL;产品规格:100g/瓶;产品用途:用于酵母杂交及遗传突变株的筛选和研究
肝浸液琼脂培养基;英文名称:Liver Infusion Agar;产品别名:肝浸液琼脂培养基基础;肝浸液琼脂培养基;使用说明:称取本品40.0g于1L蒸馏水或去离子水中,加热煮沸至完全溶解,分装,121℃高压灭菌20分钟,灭菌结束后请摇匀,以防琼脂沉积于器皿底部而凝固,备用;产品规格:250g/瓶;产品用途:用于布鲁氏菌及其它苛养菌的培养
赖安酸铁琼脂培养基;英文名称:Lysine Iron Agar;产品别名:赖安酸铁琼脂培养基基础;LIA培养基;赖安酸铁琼脂培养基(LIA);使用说明:称取本品32.0g,加热溶解于1000ml蒸馏水中,分装于13x100mm试管中,每管4ml。121℃高压灭菌15分钟,冷至60℃时,制成斜面,斜面长2.5cm,底部长4cm;产品规格:250g/瓶;产品用途:用于赖安酸脱梭、脱安及复合生化试验(FDA)
改良巴尔斯氏培养基;英文名称:Baar,s Medium for Sulfate Reducers, Modified;产品别名:改良巴尔斯氏培养基基础;改良巴尔斯氏培养基;使用说明:称取本品11.0g于1L蒸馏水或去离子水中,加热煮沸至完全溶解,分装,121℃高压灭菌15分钟,冷至55℃,每100ml添加1支含0.35g乳酸钠和0.05g磷酸氢二钾,混匀,备用;产品规格:250g/瓶;产品用途:用于脱硫肠球菌等硫酸盐还原细菌的培养,每100ml添加1支35%乳酸钠溶液
改良NBB琼脂培养基;英文名称:NBB Agar Base,Modified;产品别名:改良NBB琼脂培养基基础;改良NBB琼脂培养基;使用说明:称取本品66.3g,加入500ml蒸馏水和500ml脱气啤酒中,加热搅拌溶解,煮沸1分钟,使其彻底溶解,121℃高压灭菌15分钟,备用;产品规格:250g/瓶;产品用途:用于啤酒中厌氧菌的检测
Br紫葡萄糖蛋白胨水培养基;英文名称:Bromcresol Purple Glucose Peptone Water Medium;产品别名:Br紫葡萄糖蛋白胨水培养基基础;Br紫葡萄糖蛋白胨水培养基;使用说明:称取本品15.0g于1L蒸馏水或去离子水中,微温溶解,5ml/支分装试管,115℃灭菌40分钟,冷却,备用;产品规格:250g/瓶;产品用途:用于灭菌效果检验
Letheen琼脂培养基;英文名称:Letheen Agar Base;产品别名:Letheen琼脂培养基基础;Letheen琼脂培养基;使用说明:称取本品25.0g于1L蒸馏水或去离子,加热煮沸1分钟,分装,每100ml添加0.7g吐温80,121℃高压灭菌15分钟,倾注平板,备用;产品规格:250g/瓶;产品用途:用于化妆品卫生微生物检测,需添加7g/L吐温80
肠球菌肉汤培养基;英文名称:Enterococcus Broth;产品别名:肠球菌肉汤培养基基础;肠球菌肉汤培养基;使用说明:称取本品42.8g于1L蒸馏水或去离子水中,加热煮沸溶解,分装,121℃高压灭菌30分钟,冷却,备用;产品规格:250g/瓶;产品用途:用于肠球菌选择性菌
韦荣氏球菌琼脂培养基;英文名称:Veillonella agar Base;产品别名:韦荣氏球菌琼脂培养基基础;韦荣氏球菌琼脂培养基;使用说明:NULL;产品规格:250g/瓶;产品用途:用于韦荣氏球菌的分离和培养,每100ml培养基添加1支万古霉素溶液和2支60%乳酸钠溶液
硫酸盐还原菌培养基E;英文名称:Postgate’s Medium E for Sulfate Reducers;产品别名:硫酸盐还原菌培养基基础E;硫酸盐还原菌培养基E;使用说明:NULL;产品规格:250g/瓶;产品用途:含琼脂,用于脱硫微生物的培养和计数,每100ml添加1支35%乳酸钠溶液
酵母碳源培养基;英文名称:Yeast Carbon Base;产品别名:酵母碳源培养基基础;YCB培养基;酵母碳源培养基(YCB);使用说明:称取本品11.7g溶于100ml蒸馏水或去离子水中,加入氮源,微温溶解,过滤除菌,制成10倍浓缩液,2~8℃保存。无菌环境下,使用无菌移液器移取0.5ml上述浓缩液于4.5ml无菌蒸馏水中,混合均匀,备用;产品规格:250g/瓶;产品用途:用于通过氮源的利用对酵母菌进行分类
改良月桂基硫酸盐胰蛋白胨肉汤培养基;英文名称:Modified Lauryl Sulfate Tryptose Broth Base;产品别名:改良月桂基硫酸盐胰蛋白胨肉汤培养基基础;mLST培养基;改良月桂基硫酸盐胰蛋白胨肉汤培养基(mLST);使用说明:称取本品64.6g于1L蒸馏水或去离子水中,微温溶解,分装,121℃高压灭菌15分钟,冷至40℃以下,每100ml添加1支1mg万古霉素,分装试管,备用;产品规格:250g/瓶;产品用途:用于阪崎肠杆菌增菌,每100ml中加入万古霉素1mg
B12肉汤培养基;英文名称:B12 Assay Medium;产品别名:B12肉汤培养基基础;B12肉汤培养基;使用说明:称取本品33.0g于1L蒸馏水或去离子水中(可按比例增加或减少配制量),微温溶解,分装,121℃高压灭菌15分钟,备用;产品规格:250g/瓶;产品用途:用于维生素B12检测
硫酸盐还原菌培养基F;英文名称:Postgate’s Medium F for Sulfate Reducers;产品别名:硫酸盐还原菌培养基基础F;硫酸盐还原菌培养基F;使用说明:NULL;产品规格:250g/瓶;产品用途:含琼脂,用于脱硫微生物的培养和计数,每100ml添加1支35%乳酸钠溶液
沙门、志贺氏菌增菌培养基;英文名称:Salmonella Shigiella Enrichment Broth;产品别名:沙门、志贺氏菌增菌培养基基础;沙门、志贺氏菌增菌培养基;使用说明:称取本品63.53g,加热煮沸溶解于1000ml蒸馏水中,冷至60℃左右时,倾入无菌平皿,备用;产品规格:250g/瓶;产品用途:用于沙门氏菌、志贺氏菌的选择性增菌
LAMVAB琼脂培养基;英文名称:LAMVAB Agar Base;产品别名:LAMVAB琼脂培养基基础;LAMVAB琼脂培养基;使用说明:称取本品72.5g,加热溶解于1000ml蒸馏水中,分装,每瓶200ml,冷却至50℃左右时,加入过滤除菌的万古霉素溶液(4mg/ml)1ml,混匀,倾入无菌平皿,备用;产品规格:250g/瓶;产品用途:用于乳酸杆菌的分离,每100ml添加1支万古霉素溶液
甘露醇Cl化钠琼脂培养基;英文名称:Manitol Salt Agar;产品别名:甘露醇Cl化钠琼脂培养基基础;甘露醇盐琼脂;甘露醇Cl化钠琼脂培养基;使用说明:称取本品110.0g于1L蒸馏水或去离子水中,煮沸溶解1分钟,补水至1000ml,分装,121℃灭菌15分钟或116℃30分钟,灭菌结束后请摇匀以防琼脂沉底于底部而凝固,冷至55℃左右,备用;产品规格:250g/瓶;产品用途:用于金黄色葡萄球菌选择性分离
精安酸双水解酶试验培养基;英文名称:Double-arginine Hydrolase Test Medium;产品别名:精安酸双水解酶试验培养基基础;精安酸脱羧酶肉汤;精安酸双水解酶试验培养基;使用说明:称取本品14.0g于1L蒸馏水或去离子水中,加热煮沸至完全溶解,分装试管,每支试管滴加高约0.3mm的左右的液体石蜡,121℃高压灭菌15分钟或115℃灭菌30分钟,备用;产品规格:100g/瓶;产品用途:用于细菌的精安酸双水解酶试验
MRS培养基;英文名称:de Man, Rogosa an Medium(Modified MRS Medium Base);产品别名:MRS培养基基础;MRS琼脂;改良MRS培养基基础;MRS培养基;使用说明:称取本品64.3g于1L蒸馏水或去离子水中,加热煮沸至完全溶解,分装,121℃高压灭菌15分钟,灭菌结束后请务必摇匀,以防琼脂沉积于器皿底部而结块。若制备莫匹罗星锂盐和半胱安酸盐酸盐改良MRS培养基,冷却至55℃时无菌操作每100ml培养基中添加莫匹罗星锂盐储备液和5%半胱安酸盐酸盐溶液(MRS-半胱安酸盐酸盐培养基添加剂)各1支,摇匀,备用;产品规格:250g/瓶;产品用途:用于乳酸菌计数,改良MRS培养基每100ml需添加1支莫匹罗星锂盐储备液
M17肉汤培养基;英文名称:M17 Broth;产品别名:M17肉汤培养基基础;M17肉汤培养基;使用说明:称取本品3.g于95ml蒸馏水或去离子水中,加热煮沸至完全溶解,分装121℃高压灭菌15分钟,冷至50℃,无菌操作加入无菌的10%乳糖溶液5ml,混匀,备用;产品规格:250g/瓶;产品用途:用于牛奶和乳制品中乳酸菌的检测,每100ml添加1支10%乳糖溶液
CH培养基[含抗生素];英文名称:Cysteine Heart Blood Agar with antibiotics;产品别名:CH培养基基础[含抗生素];CH培养基[含抗生素];使用说明:NULL;产品规格:250g/瓶;产品用途:用于弯曲菌培养,每100ml添加2支溶液、2支硫酸多粘菌素B溶液、1支新生霉素储备液和10ml无菌脱纤维绵羊全血
TPY液体培养基;英文名称:TPY Broth Medium;产品别名:TPY液体培养基基础;TPY液体培养基;使用说明:称取本品26.4g于1L蒸馏水或去离子水中(可按比例增加或减少配制量),微温溶解,分装,121℃高压灭菌15分钟,冷却,备用。本品易结团,可能含有少量不溶物;产品规格:250g/瓶;产品用途:用于双歧杆菌F6PPK测定
葡萄糖半固体琼脂培养基;英文名称:Dextrose Semisolid Agar;产品别名:葡萄糖半固体琼脂培养基基础;葡萄糖半固体琼脂培养基;使用说明:称取本品31.0g于1L蒸馏水或去离子水中,加热煮沸至完全溶解,分装小试管,121℃高压灭菌15分钟,灭菌结束后直立,凝固,备用;产品规格:250g/瓶;产品用途:用于葡萄糖利用(产酸、产气)实验
马铃薯琼脂培养基;英文名称:Potato Agar;产品别名:马铃薯琼脂培养基基础;马铃薯琼脂培养基;使用说明:称取本品26.0g于1L蒸馏水或去离子水中,分装,121℃灭菌20分钟,冷却,备用;产品规格:250g/瓶;产品用途:不含葡萄糖,用于霉菌的分离培养
酵母安基酸缺陷型合成液体培养基[亮安酸缺陷];英文名称:Yeast Synthetic Drop-out Fluid Medium without Leuc;产品别名:酵母安基酸缺陷型合成液体培养基基础[亮安酸缺陷];酵母安基酸缺陷型合成液体培养基[亮安酸缺陷];使用说明:称取本品8.32g溶于1000ml蒸馏水或去离子水中,视需要加入20g葡萄糖或等量的其它碳源,微温溶解,过滤除菌,2~8℃保存;产品规格:100g/瓶;产品用途:用于酵母杂交及遗传突变株的筛选和研究
BSM无机盐培养基;英文名称:BSM Medium Base;产品别名:BSM无机盐培养基基础;BSM无机盐培养基;使用说明:称取本品38.16g于930ml蒸馏水或去离子水中,搅拌溶解,加入85%磷酸26.7ml和40g,使用100%或10g/L的硫酸铵调节pH至5.0,121℃高压灭菌15分钟或115℃灭菌30分钟,冷却后无菌操作加入4.0ml过滤除菌的PTM1(微量元素)。诱导表达前使用无菌试剂调节pH至6.0;产品规格:250g/瓶;产品用途:用于酵母菌的表达,需添加磷酸、及PTM1
安基酸脱羧酶试验对照培养基英文名称:Aminoacid Decarboxylase Test Medium controls
25%硝酸盐琼脂培养基英文名称:25% Glycerol Nitrate Agar Base
PAC斜面培养基英文名称:PAC Slant Medium
抗生素培养基1号英文名称:Medium 1(Penassay Seed Agar)
Grein-Meyers琼脂培养基英文名称:Grein and Meyers Agar(Grein and Meyers, 1958)
BPL琼脂培养基英文名称:BPL Agar
酵母安基酸缺陷型合成液体培养基[色安酸缺陷]英文名称:Yeast Synthetic Drop-out Fluid Medium without Try
麦芽汁琼脂培养基[含Cl霉素]英文名称:Malt Agar Medium with Chloramphenicol
胰酪胨大豆多粘菌素肉汤培养基英文名称:Trypticase Soy Polymyxin Broth Base
结晶紫中性红胆盐葡萄糖琼脂培养基[乳糖、葡萄糖]英文名称:Violet-Red Bile Agar with Glucose and Lactose
LB琼脂培养基[Lennox]英文名称:LB Agar,Lennox
硫酸亚铁琼脂培养基英文名称:Ferrous sulfate Agar
半固体琼脂培养基英文名称:Semisolid Agar
孟加拉红培养基英文名称:Rose Bengal Medium
抗生素培养基E[PH7.9]英文名称:Medium E(PH7.9)
CW琼脂培养基[含卡那霉素]英文名称:Clostridium Welchii Agar Base with Kanamycin
缓冲动力-硝酸盐培养基英文名称:Buffered Power-Nitrate Medium Base
胰蛋白胨葡萄糖酵母浸膏肉汤培养基基础
麦芽汁肉汤培养基英文名称:Malt Extract Broth
改良FM琼脂培养基英文名称:FM Agar, Modified
标准Ⅱ号营养琼脂培养基英文名称:Standared Ⅱ Nutrient Agar
番茄汁特制琼脂培养基英文名称:Tomato Juice Agar Special
木炭-头孢安苄血琼脂培养基英文名称:Charcoal CefalexinBlood Agar Base
改良盐琼脂培养基英文名称:Modified Sulfite Agar
碱性琼脂培养基英文名称:Alkaline Agar
改良卵磷脂琼脂培养基英文名称:Modified Letheen Agar Base
幽门螺杆菌琼脂培养基英文名称:Helicobacter pylori Agar Medium Base
赖安酸脱羧酶试验培养基英文名称:Lysine-decarboxylase Test Medium
药敏试验肉汤培养基英文名称:Sensitivity Disk Broth
RV R10肉汤培养基英文名称:Rappaport-Vassiliadis R10 broth
脑心浸出液肉汤培养基英文名称:Brain Heart Infusion Broth
"
![胰蛋白胨葡萄糖酵母浸膏肉汤培养基[源头供货]](https://img.chemicalbook.com/SupplyImg1/2025-01-27/Large/202501271901167757599.jpg)
![胰蛋白胨葡萄糖酵母浸膏肉汤培养基[最新批次]:TPGY Broth(TPGYT Base)](https://img.chemicalbook.com/SupplyImg1/2025-01-24/Large/202501240809267945261.jpg)